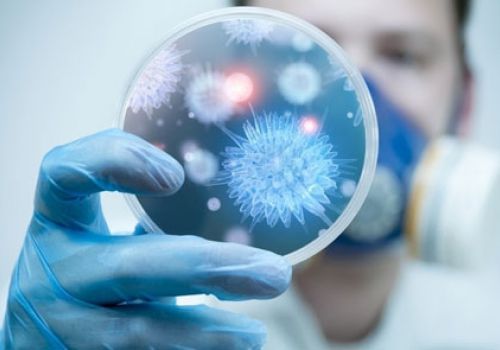
Ứng dụng công nghệ vi sinh trong nông nghiệp tại Việt Nam
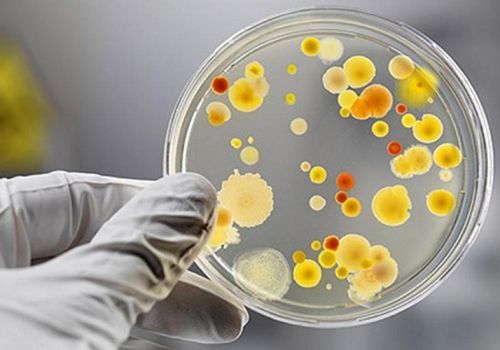
Vai trò của công nghệ vi sinh vật trong nông nghiệp

Giới thiệu
Công ty TNHH Bionatural Technologies là công ty chuyên về nghiên cứu, phát triển, sản xuất và kinh doanh công nghệ vi sinh với tư cách là một doanh nghiệp công nghệ cao, được thành lập tháng 1 năm 2017, Bionatural Technologies đã và đang phát triển các sản phẩm vi sinh có thể sử dụng trong chăn nuôi, nông nghiệp và trồng trọt… Chúng tôi sẽ tiếp tục tạo ra nhiều giá trị hơn cho khách hàng bằng cách cung cấp các chủng loại sản phẩm và dịch vụ với số lượng và chất lượng cao hơn cũng như giúp khách hàng tạo ra những sản phẩm nông nghiệp an toàn và tốt cho sức khỏe con người, xây dựng môi trường sống xanh và lành mạnh.

 Anh Tuấn - Chủ trại chăn nuôi tại Bắc Ninh
Anh Tuấn - Chủ trại chăn nuôi tại Bắc Ninh
 Anh Phương - Trại nuôi hải sản tại Vũng Tàu
Anh Phương - Trại nuôi hải sản tại Vũng Tàu
 Ông Nam - Chủ trang trại nuôi heo tại Hưng Yên
Ông Nam - Chủ trang trại nuôi heo tại Hưng Yên
Ứng dụng công nghệ vi sinh trong nông nghiệp tại Việt Nam
Ngày nay vi sinh ngày càng được ứng dụng rộng rãi trong nhiều lĩnh vực của cuộc sống như: ...
Xem chi tiết
Hoạt động nghiên cứu của Công nghệ Vi Sinh
Phòng Công nghệ Vi sinh hiện có 17 cán bộ nghiên cứu cơ hữu gồm 2 ... trong lĩnh ...
Xem chi tiết
Nghiên cứu và ứng dụng công nghệ vi sinh trong sản xuất
Nghiên cứu và ứng dụng công nghệ vi sinh trong sảnxuất chế phẩm sinh học phục vụ sảnxuất nông ...
Xem chi tiết
Vai trò của công nghệ vi sinh vật trong nông nghiệp
Từ năm 2015 đến năm 2018, Trung ương Hội tổ chức xây dựng các mô hình điểm ứng dụng ...
Xem chi tiết





